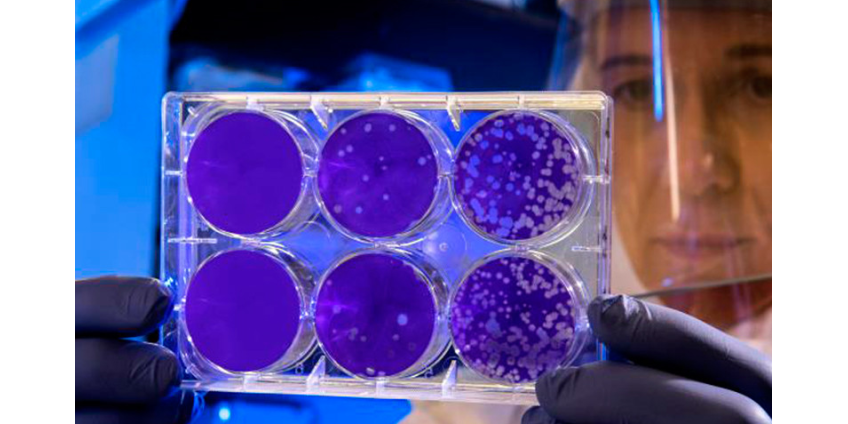
Китайский коронавирус, от которого умерли уже 9 человек, добрался до США

Теги:пневмония
В России зафиксировали всплеск заболеваемости пневмонией
Минимум в 16 регионах России зафиксировали всплеск заболеваемости пневмонией.
В Индии 15 человек стали жертвами загадочной болезни
На западе Индии 15 человек умерли от внезапно вспыхнувшей неизвестной болезни.
Разработаны микророботы для лечения пневмонии
Наноинженеры из Калифорнийского университета в Сан-Диего разработали микроскопических роботов, которые могут плавать в легких, доставлять лекарственные препараты и использоваться для лечения бактериальной пневмонии.
Новый вирус из Китая породил антикитайские настроения во многих странах мира
Новый вирус из Китая распространяется по всему миру, и одновременно растут антикитайские настроения, призывы к полному запрету на поездки китайских туристов и неприязнь к китайцам и другим азиатам, пишет агентство Associated Press.
В России выявили двоих заболевших коронавирусом нового типа
В России впервые выявили двоих заболевших коронавирусом нового типа, передает "Интерфакс" со ссылкой на заявление вице-премьера Татьяны Голиковой. Они являются гражданами Китая. Случаи выявлены в Забайкалье и Тюменской области, уточнила Голикова после заседания оперативного штаба.
В округе Сан-Диего расследуется возможный случай заболевания коронавирусом
Представители системы здравоохранения заявили в понедельник, что они расследуют первый предполагаемый случай коронавируса в округе Сан-Диего.
Власти КНР ожидают пик распространения коронавируса нового типа через 7-10 дней
Пик распространения коронавируса нового типа в КНР настанет через 7-10 дней. Об этом во вторник заявил глава специальной комиссии Государственного комитета по делам здравоохранения КНР Чжун Наньшань .
В Китае изолируют второй город в рамках борьбы против нового коронавируса
Власти Китая приняли решения с четверга запретить выезд жителей из города Хуанган, на территории которого были выявлены случаи заболевания новым опасным коронавирусом.
Китайский коронавирус, от которого умерли уже 9 человек, добрался до США
Центры по контролю и профилактике заболеваний в США (Centers for Disease Control and Prevention, CDC) подтвердили первый в стране случай заболевания коронавирусом из Китая.